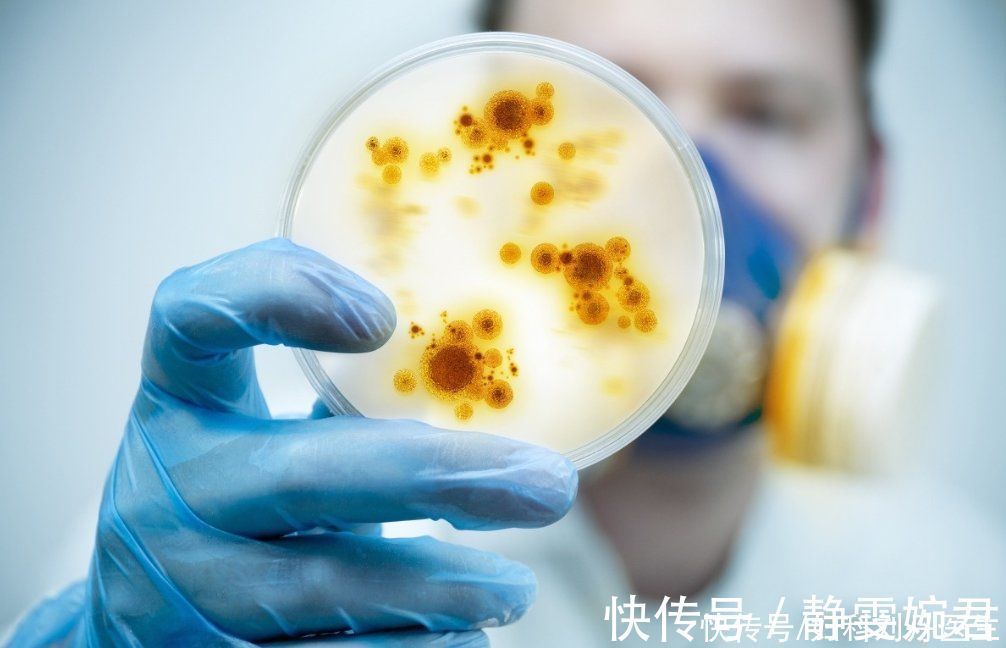
并发症|癌细胞是如何“杀死”一个人的?它喜欢你做这3件事,别给它机会

并发症|癌细胞是如何“杀死”一个人的?它喜欢你做这3件事,别给它机会
公司单位的小王最近住院了,平时小王待人亲和,为人很好,在工作上,小王总是兢兢业业,每次陪客户应酬喝酒到凌晨一两点,本来小王是不抽烟的,但是为了工作,小王也开始抽烟了,经过小王的不懈努力,小王拿下一个又一个的客户,老板也十分看重他,老板想要提升小王,但是,不料小王却生病了,十分可惜。同事们都去看望小王,才得知小王患的是癌症,大家都十分的惊讶,小王年纪轻轻的,居然患了癌症,大家询问病因,小王说“悔不如当初啊,当时只顾着陪客户,工作,忘记了自己的身体健康”,大家都十分有感触。之后,小王因为体内癌细胞扩散得太快了,导致他不但切除了胰脏和部分十二指肠,还进行肝脏移植,但是还是有部分的癌细胞藏于体内,他身体的营养已经完全被癌细胞消耗殆尽,遭受到了恶病质,器官衰竭导致了他的死亡。

文章插图
在这个事情之中,我们可以看出癌症对人体的打击是很大的,虽然癌症十分的可恶,但是我们仍然没有研发出特效治疗,癌症还是带走了很多人的生命。
对于癌细胞杀人的事件,大家可能知道的还是太浅了,下面就让我们看看癌细胞是如何夺取人类生命的呢?据科学研究表明:大抵有下面这4种情况:
1、与其他的细胞抢营养
癌症因为癌细胞大量扩散,繁殖而来。在生长繁殖的过程中,营养是必不可少的。但是癌细胞自己产生的能量是不足以让自己大量繁殖的,所以,癌细胞只能够通过抢夺其他地方的能量,而其他的部分由于缺乏营养而出现衰竭。所以有很多癌症终末期的患者是死于脏器功能衰竭。

文章插图
2、体积太大,对血管形成压迫
癌细胞既然在体内生长的话,就会需要生存的空间,但是,人体内本来是不需要它们的,所以压根就没有给它们预留位置,所以,它们就只能见缝插针了,当生长到一定程度时,癌细胞会压迫器官血管,造成血管破裂。

文章插图
3、总是“搬家”,引起并发症
癌细胞细胞膜上面的糖蛋白很少,降低了粘着性,有利于癌细胞在体内的扩散,容易引起并发症。就像:如果癌细胞扩散到肝脏,对肝细胞造成损伤,就会影响肝细胞的功能。在这之外,癌细胞会侵袭我们的免疫系统,破坏我们内环境的稳定,形成血栓,导致患者出现一系列肿瘤并发症。
文章插图
4、治疗产生副作用
其实还有一些病人并不是完全死于癌症,而是死于癌症治疗之后的副作用,副作用不但在一定程度上损害人体健康,也可能会让患者出现抑郁情绪。

文章插图
虽然癌细胞与人体是共生的关系,但是,因为癌细胞的疯长是不受控制的,所以它就会不停地扩散,直至扩散到全身。正常的细胞生长,发育,繁殖,死亡都是受基因控制的,是有一定的时间的,但是,癌细胞是基因突变得来的,它体内死亡和繁殖的基因不同,所哟,癌细胞的生长不能够得到控制。最后,癌细胞不断增长,也越来越强大。

文章插图
如果你整天良好的作息,好好地吃饭,睡觉的话,癌症会闲得无聊来找你?答案肯定是否定的,只有你做了下面这三件事来找它:
- 血压|主动脉夹层可夺命?这五类人是高危人群,需高度重视
- 进行|尿毒症多半是“吃”出来的?3种食物尽量少碰,肾或许“感谢”你
- 苹果是天然润唇膏 你知道吗?
- 生活|提醒:肝病多数是“拖”出来的,出现6种表现,最好查一下肝功
- 羊肉|羊肉到底是“致癌杀手”还是“营养佳品”呢?世卫组织揭晓答案
- 肠镜|肠镜选无痛好还是普通好?二者有何区别?不妨听听医生的分析!
- 疫情|切莫上当!这些都是流调员绝不会问的问题
- 心血管疾病|这个病还是“夫妻病”,你知道吗?
- 跑步有效延长寿命,但是晨跑和夜跑哪一个好?这才是最佳时间
- 小儿咳嗽可不都是肺热?小儿咳嗽也分好多种,你知道吗
